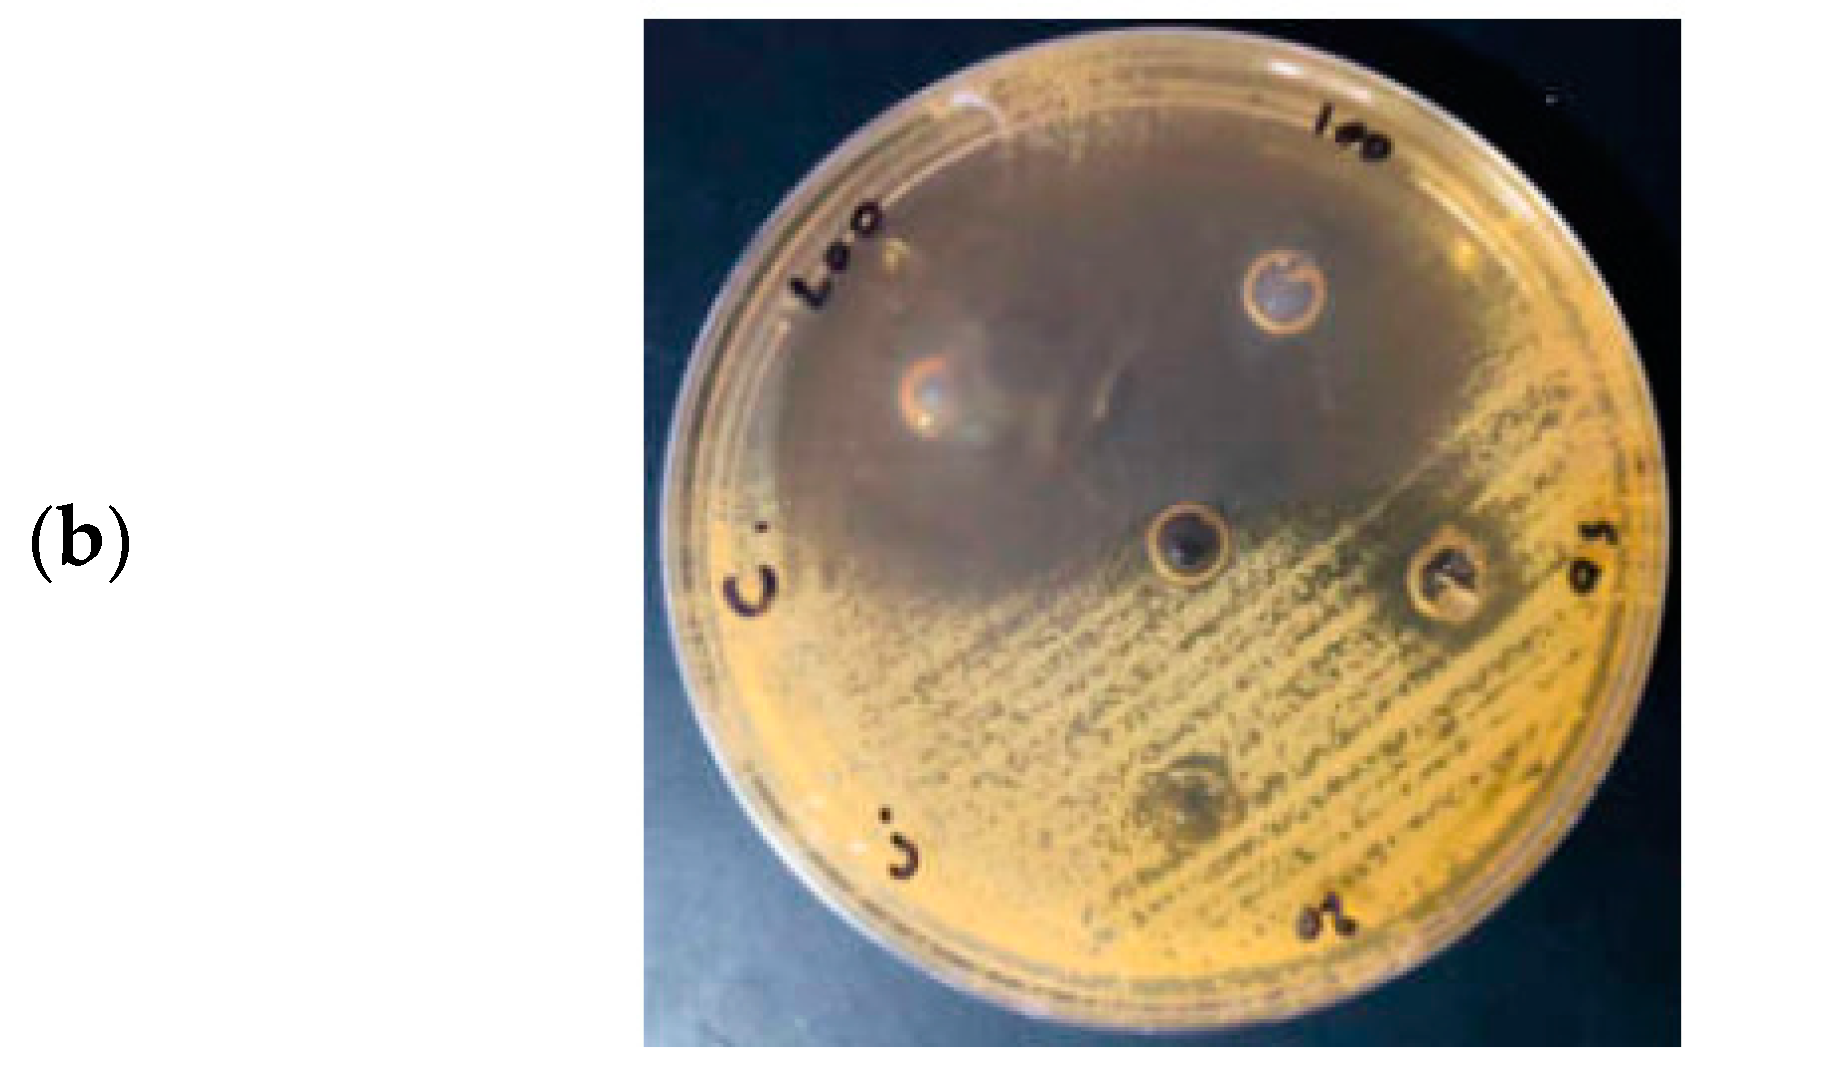

Green Synthesis of Hexagonal-like ZnO Nanoparticles Modified with Phytochemicals of Clove (Syzygium aromaticum) and Thymus capitatus Extracts: Enhanced Antibacterial, Antifungal, and Antioxidant Activities
Abstract
1. Introduction
2. Materials and Methods
2.1. Materials and Reagents
2.2. Preparation of Plant Extracts
2.3. Synthesis of Zinc Oxide Nanoparticles
2.4. Characterization of ZnO Powder Particles
2.5. Antioxidant Activity Assay
2.6. Antibacterial Activity Assay
2.7. Statistical Analysis
3. Results and Discussions
3.1. Green Synthesis of Hexagonal ZnO NPs
3.2. Optimization of the Synthesis Process
3.3. Morphological and Elemental Analysis
3.4. XRD Analysis of Hexagonal ZnO NPs
3.5. UV–Vis Analysis of Hexagonal ZnO NPs
3.6. Antioxidant Activity of Hexagonal ZnO NPs
3.7. Antibacterial Activity of Hexagonal ZnO NPs
3.8. Antifungal Activity of Hexagonal ZnO NPs
3.9. Evaluation of Previous Studies
4. Conclusions
Author Contributions
Funding
Institutional Review Board Statement
Informed Consent Statement
Data Availability Statement
Conflicts of Interest
References
- Raza, A.; Sayeed, K.; Naaz, A.; Muaz, M.; Islam, S.N.; Rahaman, S.; Sama, F.; Pandey, K.; Ahmad, A. Green Synthesis of ZnO Nanoparticles and Ag-Doped ZnO Nanocomposite Utilizing Sansevieria trifasciata for High-Performance Asymmetric Supercapacitors. ACS Omega 2024, 9, 32444–32454. [Google Scholar] [CrossRef]
- Mousa, S.A.; Wissa, D.A.; Hassan, H.H.; Ebnalwaled, A.A.; Khairy, S.A. Enhanced Photocatalytic Activity of Green Synthesized Zinc Oxide Nanoparticles Using Low-Cost Plant Extracts. Sci. Rep. 2024, 14, 16713. [Google Scholar] [CrossRef]
- Aderibigbe, B.A. Zinc Oxide Nanoparticles in Biomedical Applications: Advances in Synthesis, Antimicrobial Properties, and Toxicity Considerations. In Nanoparticles in Modern Antimicrobial and Antiviral Applications. Nanotechnology in the Life Sciences; Kokkarachedu, V., Sadiku, R., Eds.; Springer: Cham, Switzerland, 2024; pp. 119–149. [Google Scholar] [CrossRef]
- Sharma, N.; Gupta, P.C.; Upadhyay, S.; Rai, S.; Mishra, P. Antimicrobial Applications of Zinc Oxide Nanoparticles in Food Packaging Industry. In Metal and Metal-Oxide Based Nanomaterials: Synthesis, Agricultural, Biomedical and Environmental Interventions; Springer: Singapore, 2024. [Google Scholar] [CrossRef]
- Rashid, M.H.; Sujoy, S.I.; Rahman, M.S.; Haque, M.J. Aloe Vera Assisted Green Synthesis of Ag and Cu Co-Doped ZnO Nanoparticles and a Comprehensive Analysis of Their Structural, Morphological, Optical, Electrical and Antibacterial Properties. Heliyon 2024, 10, e25438. [Google Scholar] [CrossRef] [PubMed]
- Sanjeev, N.O.; Valsan, A.E. Photocatalytic and Antibacterial Activity of Green Synthesized and Immobilized Zinc Oxide Nanoparticles for the Removal of Sulfadiazine and Acetaminophen: Effect of Operational Parameters and Degradation Pathway. J. Environ. Chem. Eng. 2024, 12, 112649. [Google Scholar] [CrossRef]
- Vijayaram, S.; Razafindralambo, H.; Sun, Y.Z.; Vasantharaj, S.; Ghafarifarsani, H.; Hoseinifar, S.H.; Raeeszadeh, M. Applications of Green Synthesized Metal Nanoparticles—A Review. Biol. Trace Elem. Res. 2024, 202, 360–386. [Google Scholar] [CrossRef] [PubMed]
- Hussain, R.T.; Hossain, M.S.; Shariffuddin, J.H. Green Synthesis and Photocatalytic Insights: A Review of Zinc Oxide Nanoparticles in Wastewater Treatment. Mater. Today Sustain. 2024, 26, 100764. [Google Scholar] [CrossRef]
- Hayat, K.; Din, I.U.; Alam, K.; Khan, F.U.; Khan, M.; Mohamed, H.I. Green Synthesis of Zinc Oxide Nanoparticles Using Plant Extracts of Fumaria officinalis and Peganum harmala and Their Antioxidant and Antibacterial Activities. Biomass Convers. Biorefin. 2024. [Google Scholar] [CrossRef]
- Sharma, D.; Kanchi, S.; Bisetty, K. Biogenic Synthesis of Nanoparticles: A Review. Arab. J. Chem. 2019, 12, 3576–3600. [Google Scholar] [CrossRef]
- Motelica, L.; Vasile, B.S.; Ficai, A.; Surdu, A.V.; Ficai, D.; Oprea, O.C.; Dobre, A.A. Antibacterial Activity of Zinc Oxide Nanoparticles Loaded with Essential Oils. Pharmaceutics 2023, 15, 2470. [Google Scholar] [CrossRef]
- Singh, K.; Bano, A.; Sharma, R.; Sharma, S. Terpenoids in Nanomaterials: Synthesis, Characterization, and Their Application. In Secondary Metabolites Based Green Synthesis of Nanomaterials and Their Applications; Springer: Singapore, 2023. [Google Scholar]
- Wang, Q.; Xu, S.; Zhong, L.; Zhao, X.; Wang, L. Effects of Zinc Oxide Nanoparticles on Growth, Development, and Flavonoid Synthesis in Ginkgo biloba. Int. J. Mol. Sci. 2023, 24, 15775. [Google Scholar] [CrossRef]
- Ilangovan, A.; Venkatramanan, A.; Thangarajan, P.; Saravanan, A.; Rajendran, S.; Kaveri, K. Green Synthesis of Zinc Oxide Nanoparticles (ZnO NPs) Using Aqueous Extract of Tagetes Erecta Flower and Evaluation of Its Antioxidant, Antimicrobial, and Cytotoxic Activities on HeLa Cell Line. Curr. Biotechnol. 2020, 10, 61–76. [Google Scholar] [CrossRef]
- Selim, Y.A.; Azb, M.A.; Ragab, I.H.M.; Abd El-Azim, M. Green Synthesis of Zinc Oxide Nanoparticles Using Aqueous Extract of Deverra tortuosa and Their Cytotoxic Activities. Sci. Rep. 2020, 10, 3445. [Google Scholar] [CrossRef]
- MuthuKathija, M.; Sheik Muhideen Badhusha, M.; Rama, V. Green Synthesis of Zinc Oxide Nanoparticles Using Pisonia Alba Leaf Extract and Its Antibacterial Activity. Appl. Surf. Sci. Adv. 2023, 15, 100400. [Google Scholar] [CrossRef]
- Shaik, A.M.; David Raju, M.; Rama Sekhara Reddy, D. Green Synthesis of Zinc Oxide Nanoparticles Using Aqueous Root Extract of Sphagneticola trilobata Lin and Investigate Its Role in Toxic Metal Removal, Sowing Germination and Fostering of Plant Growth. Inorg. Nano-Met. Chem. 2020, 50, 569–579. [Google Scholar] [CrossRef]
- Bouttier-Figueroa, D.C.; Cortez-Valadez, M.; Flores-Acosta, M.; Robles-Zepeda, R.E. Green Synthesis of Zinc Oxide Nanoparticles Using Plant Extracts and Their Antimicrobial Activity. Bionanoscience 2024. [Google Scholar] [CrossRef]
- Nazneen, S.; Sultana, S. Green Synthesis and Characterization of Cissus quadrangularis. L Stem Mediated Zinc Oxide Nanoparticles. Plant Sci. Arch. 2024, 1, 1–5. [Google Scholar] [CrossRef]
- Al-darwesh, M.Y.; Ibrahim, S.S.; Mohammed, M.A. A Review on Plant Extract Mediated Green Synthesis of Zinc Oxide Nanoparticles and Their Biomedical Applications. Results Chem. 2024, 7, 101368. [Google Scholar] [CrossRef]
- Babayevska, N.; Przysiecka, Ł.; Iatsunskyi, I.; Nowaczyk, G.; Jarek, M.; Janiszewska, E.; Jurga, S. ZnO Size and Shape Effect on Antibacterial Activity and Cytotoxicity Profile. Sci. Rep. 2022, 12, 8148. [Google Scholar] [CrossRef]
- Owais Mushtaq, S.; Sharma, R.; Agrawal, A.; Sharma, A.; Kumar, S.; Awasthi, K.; Yadav, C.S.; Awasthi, A. Green Synthesis of ZnO Nanoparticles from Saffron Corm Extract and Their Bactericidal Activity. Mater. Today Proc. 2022, 69, 74–81. [Google Scholar] [CrossRef]
- Sadanandan, B.; Murali Krishna, P.; Kumari, M.; Vijayalakshmi, V.; Nagabhushana, B.M.; Vangala, S.; Singh, H.K.; Divya Swaroopa, B.R.; Megala, V. Zinc Oxide Nanoparticles Exhibit Anti-Cancer Activity against Human Cell Lines. J. Mol. Struct. 2024, 1305, 137723. [Google Scholar] [CrossRef]
- Shnawa, B.H.; Jalil, P.J.; Mhammedsharif, R.M.; Faqe, B.A.; Ahmed, M.H.; Ibrahim, H.N.; Ahmed, M.H. Synthesis, Characterization, and Evaluation of Antioxidant, Anti-Inflammatory, and Antimicrobial Activities of Zinc Oxide Nanoparticles Using Adiantum capillus-veneris L. Leaf Extract. Part. Part. Syst. Charact. 2024, 2400005. [Google Scholar] [CrossRef]
- Gudkov, S.V.; Burmistrov, D.E.; Serov, D.A.; Rebezov, M.B.; Semenova, A.A.; Lisitsyn, A.B. A Mini Review of Antibacterial Properties of ZnO Nanoparticles. Front. Phys. 2021, 9, 641481. [Google Scholar] [CrossRef]
- Lopez-Miranda, J.L.; Molina, G.A.; González-Reyna, M.A.; España-Sánchez, B.L.; Esparza, R.; Silva, R.; Estévez, M. Antibacterial and Anti-inflammatory Properties of ZnO Nanoparticles Synthesized by a Green Method Using Sargassum Extracts. Int. J. Mol. Sci. 2023, 24, 1474. [Google Scholar] [CrossRef]
- Skrajnowska, D.; Bobrowska-Korczak, B. Role of Zinc in Immune System and Anti-cancer Defense Mechanisms. Nutrients 2019, 11, 2273. [Google Scholar] [CrossRef]
- Abbaszadeh, A.; Hosseini, H.; Rajabzadeh, A.; Zarei, L. Histopathological Evaluation of the Application of Zinc Nanoparticles in Conjunction with Chitosan Dressing on the Wound Healing of Methicillin-Resistant Staphylococcus aureus Infected Skin Wounds in Rats. Crescent J. Med. Biol. Sci. 2023, 11, 98–106. [Google Scholar] [CrossRef]
- Faisal, S.; Jan, H.; Shah, S.A.; Shah, S.; Khan, A.; Akbar, M.T.; Rizwan, M.; Jan, F.; Wajidullah; Akhtar, N. Green Synthesis of Zinc Oxide (ZnO) Nanoparticles Using Aqueous Fruit Extracts of Myristica fragrans: Their Characterizations and Biological and Environmental Applications. ACS Omega 2021, 6, 9709–9722. [Google Scholar] [CrossRef]
- Ahsan, A.; Farooq, M.A.; Bajwa, A.A.; Parveen, A. Green Synthesis of Silver Nanoparticles Using Parthenium Hysterophorus: Optimization, Characterization and in Vitro Therapeutic Evaluation. Molecules 2020, 25, 3324. [Google Scholar] [CrossRef]
- Bandeira, M.; Giovanela, M.; Roesch-Ely, M.; Devine, D.M.; da Silva Crespo, J. Green Synthesis of Zinc Oxide Nanoparticles: A Review of the Synthesis Methodology and Mechanism of Formation. Sustain. Chem. Pharm. 2020, 15, 100223. [Google Scholar] [CrossRef]
- Youssef, F.S.; Ismail, S.H.; Fouad, O.A.; Mohamed, G.G. Green Synthesis and Biomedical Applications of Zinc Oxide Nanoparticles. Egypt. J. Vet. Sci. 2024, 55, 287–311. [Google Scholar] [CrossRef]
- Wesolowska, A.; Grzeszczuk, M.; Jadczak, D. Comparison of the Chemical Composition of Essential Oils Isolated by Water-Steam Distillation and Hydrodistillation from Garden Thyme (Thymus vulgaris L.). J. Essent. Oil Bear. Plants 2016, 19, 832–842. [Google Scholar] [CrossRef]
- Brand-Williams, W.; Cuvelier, M.E.; Berset, C. Use of a Free Radical Method to Evaluate Antioxidant Activity. LWT Food Sci. Technol. 1995, 28, 25–30. [Google Scholar] [CrossRef]
- Ardjani, T.E.A.; Alvarez-Idaboy, J.R. Radical Scavenging Activity of Ascorbic Acid Analogs: Kinetics and Mechanisms. Theor. Chem. Acc. 2018, 137, 69. [Google Scholar] [CrossRef]
- Jyoti, M.; Vijay, D.M.; Radha, S. To Study the Role of Temperature and Sodium Hydroxide Concentration in the Synthesis of Zinc Oxide Nanoparticles. Int. J. Sci. Res. Publ. 2013, 3, 2250–3153. [Google Scholar]
- Velsankar, K.; Sudhahar, S.; Parvathy, G.; Kaliammal, R. Effect of Cytotoxicity and Antibacterial Activity of Biosynthesis of ZnO Hexagonal Shaped Nanoparticles by Echinochloa frumentacea Grains Extract as a Reducing Agent. Mater. Chem. Phys. 2020, 239, 121976. [Google Scholar] [CrossRef]
- Bounatirou, S.; Smiti, S.; Miguel, M.G.; Faleiro, L.; Rejeb, M.N.; Neffati, M.; Pedro, L.G. Chemical Composition, Antioxidant and Antibacterial Activities of the Essential Oils Isolated from Tunisian Thymus capitatus Hoff. et Link. Food Chem. 2007, 105, 146–155. [Google Scholar] [CrossRef]
- Dey, A.; Somaiah, S. Green Synthesis and Characterization of Zinc Oxide Nanoparticles Using Leaf Extract of Thryallis glauca (Cav.) Kuntze and Their Role as Antioxidant and Antibacterial. Microsc. Res. Tech. 2022, 85, 2835–2847. [Google Scholar] [CrossRef]
- Barhoum, A.; Melcher, J.; Van Assche, G.; Rahier, H.; Bechelany, M.; Fleisch, M.; Bahnemann, D. Synthesis, Growth Mechanism, and Photocatalytic Activity of Zinc Oxide Nanostructures: Porous Microparticles versus Nonporous Nanoparticles. J. Mater. Sci. 2016, 52, 2746–2762. [Google Scholar] [CrossRef]
- Zahli, R.; Abrini, J.; El Baaboua, A.; Belmehdi, O.; El Maadoudi, M.; Souhail, B.; El Issaoui, K.; Senhaji, N.S. Synergistic Action of Thymus capitatus and Syzygium aromaticum Essential Oils in Combination with Antibiotics Against Multi-Resistant Salmonella Strains. Biocatal. Agric. Biotechnol. 2023, 50, 102752. [Google Scholar] [CrossRef]
- El-Maati, M.F.A.; Mahgoub, S.A.; Labib, S.M.; Al-Gaby, A.M.A.; Ramadan, M.F. Phenolic Extracts of Clove (Syzygium aromaticum) with Novel Antioxidant and Antibacterial Activities. Eur. J. Integr. Med. 2016, 8, 494–504. [Google Scholar] [CrossRef]
- Tamma, N.; Benchikha, N.; Messaoudi, M.; Caruso, G.; Emran, T.B.; Atoki, A.V.; Adeniyi, A.I. Chemical Composition and Biological Properties of Thymus capitatus Plants from Algerian High Plains: A Comparative and Analytical Study. Open Chem. 2024, 22, 20230192. [Google Scholar] [CrossRef]
- Chaudhary, A.; Kumar, N.; Kumar, R.; Salar, R.K. Antimicrobial Activity of Zinc Oxide Nanoparticles Synthesized from Aloe vera Peel Extract. SN Appl. Sci. 2019, 1, 136. [Google Scholar] [CrossRef]
- Ong, C.B.; Ng, L.Y.; Mohammad, A.W. A Review of ZnO Nanoparticles as Solar Photocatalysts: Synthesis, Mechanisms and Applications. Renew. Sustain. Energy Rev. 2018, 81, 536–551. [Google Scholar] [CrossRef]
- Alhujaily, M.; Albukhaty, S.; Yusuf, M.; Mohammed, M.K.A.; Sulaiman, G.M.; Al-Karagoly, H.; Alyamani, A.A.; Albaqami, J.; AlMalki, F.A. Recent Advances in Plant-Mediated Zinc Oxide Nanoparticles with Their Significant Biomedical Properties. Bioengineering 2022, 9, 541. [Google Scholar] [CrossRef] [PubMed]
- Raghupathi, K.R.; Koodali, R.T.; Manna, A.C. Size-dependent bacterial growth inhibition and mechanism of antibacterial activity of zinc oxide nanoparticles. Langmuir 2011, 27, 4020–4028. [Google Scholar] [CrossRef] [PubMed]
- Yassin, M.T.; Mostafa, A.A.-F.; Al-Askar, A.A.; Al-Otibi, F.O. Facile Green Synthesis of Zinc Oxide Nanoparticles with Potential Synergistic Activity with Common Antifungal Agents against Multidrug-Resistant Candidal Strains. Crystals 2022, 12, 774. [Google Scholar] [CrossRef]
- Sharma, B.; Gupta, K.; Garg, V. Green Synthesis of ZnO Nanoparticles Using Plant Extract as a Template. In Macromolecular Symposia; Wiley Online Library: Hoboken, NJ, USA, 2024; Volume 413, p. 2200197. [Google Scholar] [CrossRef]
- Khaleel, A.I.; Mohmed, A.S.; Al-Taey, D.K.A.; Kamaluddin, Z.N. Green Synthesis of ZnO Nanoparticles Using Myrtus communis L. Extract and Their Insecticidal Activity against Myzus persicae (Sulzer). Biopestic. Int. 2023, 19, 143–148. [Google Scholar] [CrossRef]
- Chandrasekar, L.P.; Sethuraman, B.D.; Subramani, M.; Mohandos, S. Green Synthesised ZnO Nanoparticles from Plectranthus amboinicus Plant Extract: Removal of Safranin- O and Malachite Green Dyes & Anti-Bacterial Activity. Int. J. Environ. Anal. Chem. 2023. [Google Scholar] [CrossRef]
- Falih, A.; Ahmed, N.M.; Rashid, M. Green Synthesis of Zinc Oxide Nanoparticles by Fresh and Dry Alhagi Plant. Mater. Today Proc. 2020, 49, 3624–3629. [Google Scholar] [CrossRef]
- Klinbumrung, A.; Panya, R.; Pung-Ngama, A.; Nasomjai, P.; Saowalakmeka, J.; Sirirak, R. Green Synthesis of ZnO Nanoparticles by Pineapple Peel Extract from Various Alkali Sources. J. Asian Ceram. Soc. 2022, 10, 755–765. [Google Scholar] [CrossRef]
- Al Awadh, A.A.; Shet, A.R.; Patil, L.R.; Shaikh, I.A.; Alshahrani, M.M.; Nadaf, R.; Mahnashi, M.H.; Desai, S.V.; Muddapur, U.M.; Achappa, S.; et al. Sustainable Synthesis and Characterization of Zinc Oxide Nanoparticles Using Raphanus sativus Extract and Its Biomedical Applications. Crystals 2022, 12, 1142. [Google Scholar] [CrossRef]

| Exp. No. | Synthesis Conditions | Characteristics | ||||
|---|---|---|---|---|---|---|
| ZnCl2 (g) | Clove Extract (mL) | Thymus Capitatus Extract (mL) | Antioxidant (% DPPH Inhibition) | Gram-Negative K. pneumoniae (ZOI mm) | Gram-Positive B. subtilis (ZOI mm) | |
| 1 | 3.0 | 15 | 5 | 85.5 | 14 ± 0.8 | 10 ± 0.5 |
| 2 | 3.0 | 5 | 15 | 86.3 | 12 ± 0.5 | 15 ± 0.8 |
| 3 | 3.0 | 10 | 10 | 91.2 | 15 ± 0.5 | 16 ± 1.1 |
| 4 | 4.0 | 10 | 10 | 92.0 | 14 ± 1.0 | 15 ± 0.5 |
| 5 | 5.5 | 10 | 10 | 93.4 | 11 ± 0.75 | 12 ± 0.8 |
| 6 | 2.0 | 10 | 10 | 95.2 | 18 ± 0.5 | 25 ± 0.2 |
| 7 | 4.0 | 5 | 5 | 93.3 | 9 ± 0.2 | 10 ± 0.8 |
| Sample Concentration | ZnO NPs | Ascorbic Acid | ||
|---|---|---|---|---|
| Absorbance (a.u.) ± SD | DPPH Inhibition (%) | Absorbance (a.u.) ± SD | DPPH Inhibition (%) | |
| 220 µ/mL | 0.70 ± 0.01 | 30.0% | 0.69 ± 0.05 | 31.0% |
| 500 µ/mL | 0.437 ± 0.05 | 56.3% | 0.45 ± 0.02 | 55.0% |
| 750 µ/mL | 0.177 ± 0.02 | 82.3% | 0.19 ± 0.05 | 81.0% |
| 1000 µ/mL | 0.048 ± 0.01 | 95.2% | 0.11 ± 0.05 | 89.0% |
| IC50 | / | 434.06 µg/mL | / | 442.96 µg/mL |
| Microbial Strains Used | ZnO NP Dispersion | CIP (Positive Control) | Deionized Water (Negative Control) | MIC (µg/mL) | |||
|---|---|---|---|---|---|---|---|
| 200 ppm | 100 ppm | 50 ppm | 20 ppm | 5 µg/Discs | |||
| Escherichia coli ATCC 25922 | 26 ± 0.2 | 19 ± 1.1 | 10 ± 0.3 | Nill | 34 ± 0.2 | Nill | 50 |
| Salmonella typhimurium ATCC 14028 | 20 ± 1.1 | 15 ± 0.0 | Nill | Nill | 31 ± 0.5 | Nill | 100 |
| Klebsiella pneumoniae ATCC 13883 | 18 ± 0.5 | 16 ± 0.7 | 10.5 ± 0.5 | Nill | 34 ± 1.0 | Nill | 50 |
| Staphylococcus aureus ATCC 25932 | 25 ± 0.2 | 15 ± 1.0 | 10 ± 0.8 | Nill | 30 ± 0.8 | Nill | 50 |
| Staphylococcus hominis ATCC 27844 | 23 ± 0.0 | 14 ± 0.5 | 8 ± 0.0 | Nill | 29 ± 0.4 | Nill | 50 |
| Bacillus subtilis ATCC 25973 | 25 ± 1.2 | 12 ± 0.8 | 9 ± 0.2 | Nill | 24 ± 0.0 | Nill | 50 |
| Candida albicans ATCC 10231 | 35 ± 0.5 | 28 ± 0.0 | 13 ± 0.5 | 8 ± 0.2 | / | Nill | 20 |
| Plant Source | Zn Salt | Shape and Size (nm) | Drying and Annealing Conditions | Biological Properties | Ref. |
|---|---|---|---|---|---|
| Non | ZnCl2 | 20–350 nm Semi-spherical | 100 | Not tested | [36] |
| Sunflower husk | Zn nitrate | prismatic/flower shaped | Dried in a vacuum oven at 60 °C overnight | Phytoremediation of toxic chemicals from water bodies | [49] |
| Myrtus communis | Zn acetate | semi-spherical, 55 nm | dried at 60 °C overnight | Eco-friendly alternative to chemical insecticides | [50] |
| Plectranthus amboinicus | Zn sulphate | hexagonal close-packed lattice | Air dried | 90% antibacterial effectiveness against S. aureus and E. coli; 85.29% degradation of Safranin-O dye, 81.57% of Malachite green dye | [51] |
| Alhagi | Zn nitrate | mounds-like, 55 nm | dried at 60 °C overnight | No studies | [52] |
| Pineapple peel | zinc nitrate | flower-like | dried in an oven at 80 °C overnight | fascinating optical properties | [53] |
| Raphanus sativus | zinc acetate | Hexagonal wurtzite, 66 nm | dried at 50 °C | Anticancer and antibacterial, causing ROS generation and activating apoptotic pathways | [54] |
| Clove and Thymus capitatus | Zn chloride | Hexagonal, 160 nm | Dried at 80 °C and not annealed at high temperature | 95.2% antioxidant activity, potent antibacterial effects against both Gram-(+) and Gram-(−) bacteria | This work |
Disclaimer/Publisher’s Note: The statements, opinions and data contained in all publications are solely those of the individual author(s) and contributor(s) and not of MDPI and/or the editor(s). MDPI and/or the editor(s) disclaim responsibility for any injury to people or property resulting from any ideas, methods, instructions or products referred to in the content. |
© 2024 by the authors. Licensee MDPI, Basel, Switzerland. This article is an open access article distributed under the terms and conditions of the Creative Commons Attribution (CC BY) license (https://creativecommons.org/licenses/by/4.0/).
Share and Cite
Haiouani, K.; Hegazy, S.; Alsaeedi, H.; Bechelany, M.; Barhoum, A. Green Synthesis of Hexagonal-like ZnO Nanoparticles Modified with Phytochemicals of Clove (Syzygium aromaticum) and Thymus capitatus Extracts: Enhanced Antibacterial, Antifungal, and Antioxidant Activities. Materials 2024, 17, 4340. https://doi.org/10.3390/ma17174340
Haiouani K, Hegazy S, Alsaeedi H, Bechelany M, Barhoum A. Green Synthesis of Hexagonal-like ZnO Nanoparticles Modified with Phytochemicals of Clove (Syzygium aromaticum) and Thymus capitatus Extracts: Enhanced Antibacterial, Antifungal, and Antioxidant Activities. Materials. 2024; 17(17):4340. https://doi.org/10.3390/ma17174340
Chicago/Turabian StyleHaiouani, Kheira, Sherif Hegazy, Huda Alsaeedi, Mikhael Bechelany, and Ahmed Barhoum. 2024. "Green Synthesis of Hexagonal-like ZnO Nanoparticles Modified with Phytochemicals of Clove (Syzygium aromaticum) and Thymus capitatus Extracts: Enhanced Antibacterial, Antifungal, and Antioxidant Activities" Materials 17, no. 17: 4340. https://doi.org/10.3390/ma17174340
APA StyleHaiouani, K., Hegazy, S., Alsaeedi, H., Bechelany, M., & Barhoum, A. (2024). Green Synthesis of Hexagonal-like ZnO Nanoparticles Modified with Phytochemicals of Clove (Syzygium aromaticum) and Thymus capitatus Extracts: Enhanced Antibacterial, Antifungal, and Antioxidant Activities. Materials, 17(17), 4340. https://doi.org/10.3390/ma17174340

